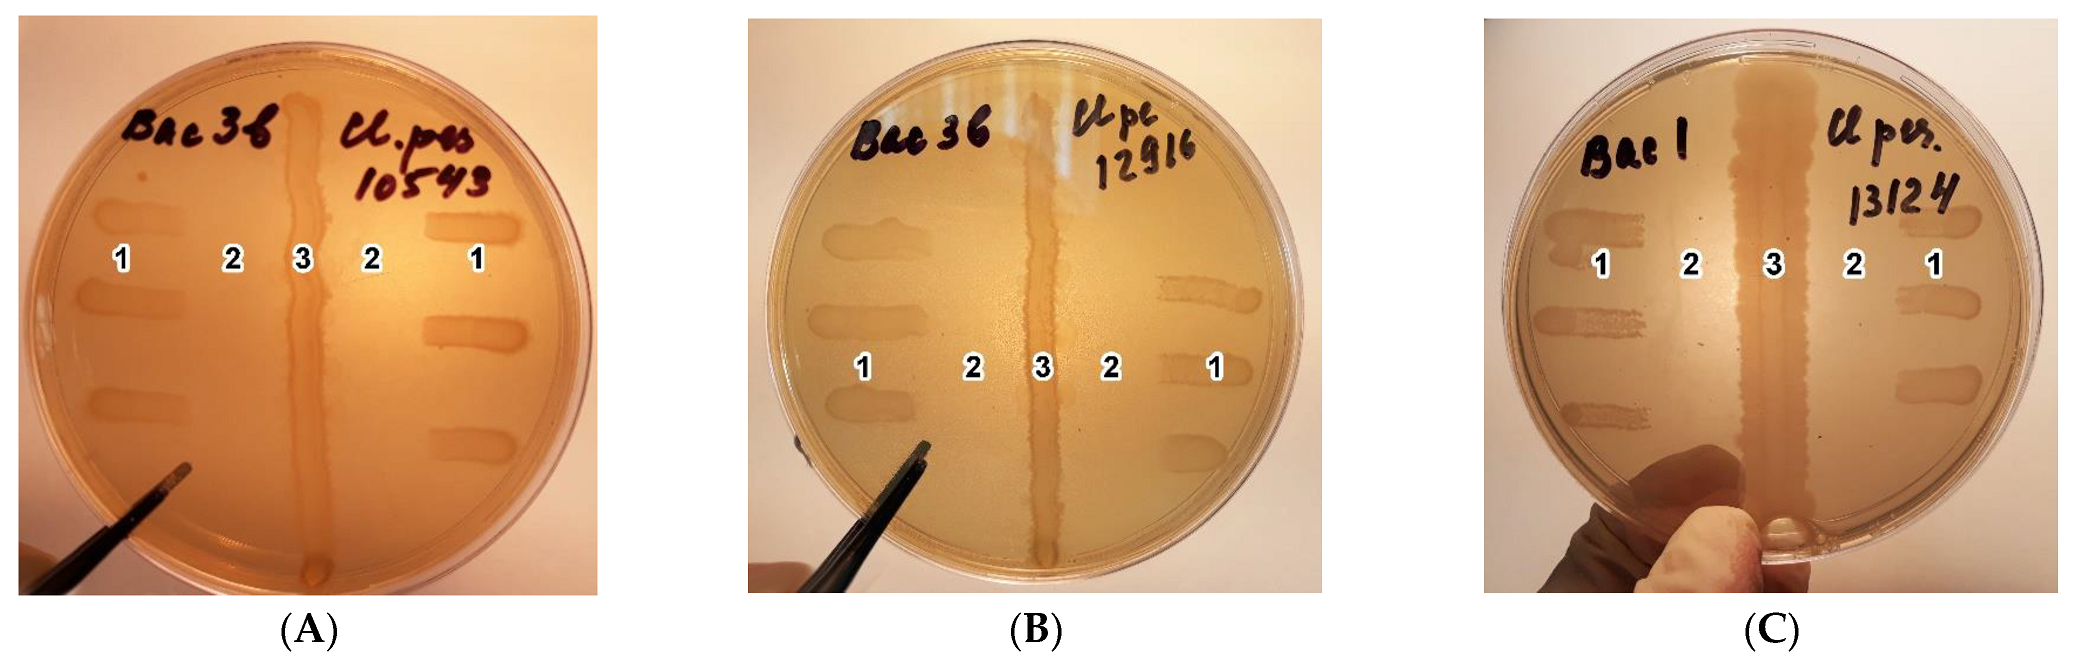
Agriculture 13 00786 g002 Agriculture 13 00786 g002

Abstract
The purpose of this research is to develop and test a new approach to prevent clostridial disease in cattle, based on the use of a new compound biologically active feed additive (BFA). Some properties of the separate components of BFA are characterized. The research showed that a strain of the bacterium Bacillus amyloliquefaciens159 has an expressed antagonism to toxin-producing strains of C. perfringens. When using the test strains of C. perfringens from the ATCC collection (13,124 as type A, 10,543 as type C, 12,916 as type F), the anticlostridial activity of the tested strains varied, with size range of 14.0 ± 0.95–15.0 ± 1.28 mm of delayed growth zones. The bactericidal properties of lauric acid and the sorption properties of diatomaceous earth, included in BFA, were confirmed. The experiment was conducted on Holstein cows at the beginning of lactation (control, C (n = 15) vs. experimental E48 (n = 15), E80 (n = 15) and E112 (n = 15), 48, 80 and 112 g/head/day BFA, respectively. All cows were vaccinated with “Coglavax” (vaccine against bovine and sheep clostridial disease, Ceva-Phylaxia VeterinaryBiologicals, Hungary), reinjected two weeks before the experiment. At the end of the experiment (3.5 months after the vaccination and 3 months after the start of BFA feeding according to the scheme of the experiment), the immune response in the control and Group E48 to C. perfringens β-toxin remained at the initial level, while the response in Group E80 and Group E112 became higher under the influence of BFA feeding. Cows fed BFA saw a guaranteed improvement in non-specific resistance. The increase in serum lysozyme concentration in cows of Groups E was 1.01–2.91 mkg/mL vs. control (p < 0.001). TP, GLB, ALB/GLB vs. Groups C and E48 (p < 0.001); this stabilized and normalized while feeding Group E80 and E112 animals with BFA. They also had improved nitrogen, fat, mineral metabolism, as indicated by significant increase in ALB (p < 0.05), UREA (p < 0.01), CHOL (p < 0.01), and CHL (p < 0.01) vs. Groups C and E48. Consumption of BFA increased the amount of anti-oxidants in the blood (highest TAWSA values in Group E80 14.45 mg/g, p = 0.002). Serum TBA–AP/ CP ratio was directly related to TBA–AP (r = 0.87, p < 0.001), and decreased in Group E80. The milk productivity increased under the action of BFA; the average daily milk yield of the cows from the experimental groups for the period of the experiment (d0–d98) was 1.24–1.66 kg higher than that of the control. At the same time, Group E112 cows had a significant increase in milk yield (by 5.1%, p = 0.03 vs. Control). Thus, feeding BFA to dairy cows was found to improve resistance, prevent toxicoses and increase milk production of cattle, which can serve as an additional strategy for bioprotection of cattle against infection.
1. Introduction
Even if all feed production requirements are met, there are risks of xenobiotics of various etiologies entering the feed [1]. Once in animals, they cause serious health problems, can biotransform and accumulate in animal products, and thereby cause harm, not only to animals, but also to humans [2,3].
Meanwhile, animals consuming feeds containing various groups of xenobiotics suffer from damage to the limbs, liver, and digestive organs, metabolic disorders, postnatal complications, and reproductive disorders [4]. Often, contaminants of fungal (mycotoxins), bacterial (exo- and endotoxins), and chemical origin (pesticides and heavy metals) are present simultaneously in the feed, which has a synergistic negative effect on the animal organism [5,6,7].
The accumulation of xenobiotics determines changes in the intracellular content of dissolved substances, which can lead to volume changes, called isoosmotic volume changes, since the plasma membrane is easily permeable to water, and under normal conditions the body is able to conduct a rapid, multidirectional water flow to establish equilibrium, which is often disturbed by various pollutants [8,9]. This disturbance in the body can reach a state of oxidative stress when the balance between oxidants and antioxidants is disturbed. Stresses, including oxidative stress, are a special case of metabolic disorders, in which improper feeding and housing contribute to higher levels of endo- and exotoxins entering the bloodstream, causing inflammation in the animals, with a significant decrease in productivity [10].
For many years, it was believed that ruminants have absolute resistance to mycotoxins. However, the metabolism of mycotoxins in the rumen is not equivalent to their complete detoxification. Furthermore, their potential degradation depends to a large extent on the stability of the rumen microbial community and the pH, which varies depending on the feed composition [11]. It is known that high-yielding cows, transition cows, and calves are the most demanding in terms of optimal feeding and housing conditions. As a result of selection solely for milk productivity, low resistance, increased sensitivity to stresses, and pathological reaction to even insignificant changes in cattle maintenance and feeding are often observed in high-productivity cows. The presence of toxigens in feed is a factor leading to subclinical pathological conditions with a negative dynamic which, in the absence of a precise diagnosis and qualified help, is highly likely to lead to a fatal outcome. A typical example of this trend is the large number of high-yielding cattle that are culled immediately after calving or in the first months of lactation [12]. According to Hadley et al. [13], up to 80% of culled dairy cows have health problems.
The presence of toxins in feed primarily affects the rumen microflora, as many secondary metabolites are produced during digestion, negatively affecting numerous groups of microorganisms living in the rumen [14]. It is therefore a proven fact that ruminants are more affected by natural and natural pollutants than other species [15].
Many studies have been conducted on the effects of chemical toxins [16] and mycotoxins [17] on the ruminant organism. Mechanisms have also been developed to mitigate their effects on the animal organism, primarily related to measures to reduce emissions into the environment, to improve protocols for forage harvesting and storage, and to neutralize and remove them from the animal organism by feeding them targeted feed additives [18,19,20].
Bacterial toxins are no less dangerous [21]. It is well known that the secretion of proteins that damage host tissue is an integral part of the infectious processes of many bacterial pathogens [22,23]. In addition, toxins can be produced by many bacteria that live harmlessly in the animal’s body—representatives of normal and opportunistic microflora: Escherichia coli, Campylobacter spp., Shigella spp., Staphylococcus spp., Bacillus spp., Clostridium spp., etc. Individual species of these can cause infection, either by reaching a specific organ or under the influence of certain conditions [24].
Much work has been undertaken to eliminate and/or reduce the incidence of anaerobic infections in veterinary medicine. Even today, despite the availability of specific prophylactics, chemotherapeutic agents, and antibiotics against most infections, clostridia remains a serious problem and causes considerable economic damage [25,26].
The pathogenic anaerobic microorganisms that are the causative agents of clostridia are widespread in nature [27]. Their main reservoir is soil, and they also live in the intestines of animals and humans. Most clostridia are toxigenic infections. Exposure occurs through the formation of highly active toxins during growth, but other pathogenicity factors (hyaluronidase, lecithinase, collagenase, haemolysins, etc.) are also present. Clinically relevant clostridium species include the causative agents of independent diseases: tetanus, botulism, and emphysema, for example. However, in most cases the disease is caused by an association of species, as well as other anaerobes and aerobes. Although the clinical features of anaerobic diseases caused by different clostridial species differ greatly, there are several features that allow them to be grouped under the common name of Clostridiosis. These features include the ability to form spores, the anaerobic nature of the metabolic processes, the formation of highly active exotoxins, their habitation within animal intestines, and the fact that they often affect young animals with well-developed musculature [28].
In humans and livestock, C. perfringens causes intestinal infections, such as enteritis, enterocolitis, or enterotoxaemia. Enterotoxaemia in cattle is an acute or subacute syndrome with a mortality rate close to 100%, and is associated with the uncontrolled multiplication of C. perfringens in the small intestine, with excessive production of toxins [29]. These toxins act both locally and systemically, and can cause death within minutes to hours [30].
Often, the problem of clostridial disease, as well as the development of mycotoxicoses, is associated with a failure to follow the technology of canned feed production, which results in secondary fermentation in the feed and proliferation of proteolytic bacteria, mainly clostridia. Cattle are most at risk during the grazing season, which means that disease control and prevention should be particularly targeted at this time of year [31].
As all vaccines against clostridial disease are inactivated, two doses must be administered to heifers. In practice, however, the vaccinations are often administered too late, according to expert observations, and they are not always successful. In addition, spore-forming clostridia are resistant to broad-spectrum antibiotics, so their uncontrolled use in livestock further increases the risk of clostridial infections [32].
One way of combating clostridial disease is to develop an integrated animal bioprotection function. The bioprotection function is based on a scientifically proven combination of sorbents and toxin degraders, with carefully selected biologically active substances to improve the functioning of the digestive system and restore the function of the immune system in animals [33].
Anaerobic infections are a major problem for animal production worldwide. The damage consists of losses, not only from animal deaths, but also from unfavorable conditions in areas contaminated with pathogen spores and losses from quarantine measures and restrictions [21]. The economic damage caused by reduced productivity can only be estimated approximately. Therefore, in addition to proper vaccination, additional means are needed to provide full protection against and prevention of clostridia, including the use of feed additives that neutralize not only the toxins, but also the clostridia themselves, and their spores [34].
Research on the efficacy of feed additives for the prevention of clostridia in animals is still insufficient. It is of interest to study approaches to feeding animals complexes of substances that neutralize clostridia and/or their toxins. A new complex feed additive for dairy cows, which combines the functions of a sorbent, an immunomodulator, and a neutralizer, has been developed. Considering the specific character of the question under study, we have set an objective to investigate, on the one hand, the background values of clostridia presence in a modern Russian farm with a high level of fodder production and cattle breeding. On the other hand, we intend to reveal the possibility of preventing and increasing the immune status of cows with high productivity using a targeted bioactive feed additive, which can play an important role in the formation of new approaches in the integrated control of clostridia and its sequelae.
2. Materials and Methods
2.1. Study Site
The research was carried out on the grounds of Avangard LLC, located in the Ryazan region, Russia; in the laboratories of the feeding department, physiology and biochemistry department, and microbiology laboratory of farm animals at L.K. Ernst Federal Research Center for Animal Husbandry (FRCAH), located in Podolsk, Russia; in the laboratory of molecular and genetic studies of Biotroph Ltd., located in St. Petersburg, Russia.
2.2. Characteristics of the Compound Feed Additive
2.2.1. Composition of the Feed Additive
Bioactive feed additive (BFA) contains a toxin neutralizer, digestion modifiers, and natural substances of antibacterial nature (diatomite, enzyme–probiotic preparation, etc.).
For the experiment, experimental batches of multifunctional BFA were prepared. Composition of the additive, in 100 g:
- (1)
- enzyme–probiotic component
- -
- B. amyloliquefaciens159—not less than 6 × 107 CFU/g–0.1 g;
- (2)
- antibacterial component
- -
- lauric acid—4.2 g;
- -
- pine bark extract (aqueous)—8.3 g;
- -
- essential oil—0.064 g;
- (3)
- sorbent constituent
- -
- diatomite—40 g;
- -
- wheat bran (as a filler)—55.8 g.;
The strain B. amyloliquefaciens159 was obtained from the collection of BIOTROF LLC (St. Petersburg, Russia). The original strain was extracted from the chyme of cow rumen. It is not a genetically modified organism.
The taxonomic identity of strain B. amyloliquefaciens159 was previously confirmed by whole-genome sequencing using the MiSeq platform (Illumina, Inc., San Diego, CA, USA). Application has been made (SUB12907853; Taxonomy ID: 3029762; BioProject ID: PRJNA937299) to deposit the genomic sequence in the BioProjects collection (NCBI, https://www.ncbi.nlm.nih.gov/bioproject/ (accessed on 21 Febuary 2023)).
According to the data obtained using conventional methods [35,36,37] strain B. amyloliquefaciens159 has no properties of toxigenicity and virulence, cell components of the strain are not toxic to laboratory animals.
Strain B. amyloliquefaciens159 was cultured at 37 °C on GRM nutrient broth medium of the following composition (g/L): enzymatic peptone, pancreatic hydrolysate of fish meal, sodium chloride, pH = 7.2 ± 0.2. (Siana LLC, Izhevsk, Russia).
2.2.2. Component Properties of the Feed Additive
In the laboratory of molecular genetic studies of Biotroph Ltd.:
- -
- Anticlostridial activity of B. amyloliquefaciens159 strains was determined. A daily culture of B. amyloliquefaciens159 strain at a concentration of 1 × 108 CFU/mL, (grown on GRM nutrient broth at 37 °C for 24 h) was seeded with one linear stroke (strip) on the surface of dense RCB and blood agar media (BIOMEDIA LLC, Russia) along the diameter of a Petri dish, using a sterile swab. The cultures were incubated at 37 °C for 24 h. C. perfringens indicator strains from the American Type Culture Collection (ATCC) [38,39] (13124, 10543, 12916) were seeded in tubes with thioglyco-left medium and incubated at 37 °C for 24 h under anaerobic conditions using Gaz Pak Anaerobe Container System (BD) (Thermo Fisher Scientific Inc., Waltham, USA). The results were evaluated according to GPhM. 1.7.2.0009.15 (Determination of the specific activity of probiotics) [40]. The size of the no-growth zone of the test strain was considered. C. perfringens belonged to different toxinotypes [41]. Strain C. perfringens 13124 belongs to type A, because it produces alpha toxin (CPA), and perfringolysin O (PfoA), C. perfringens 12916 (type F) synthesizes CPA, and enterotoxin (CPE), C. perfringens 10543 (type C) simultaneously produces 4 toxins, CPA, CPE, beta2 toxin (CPB2), Pfoa. This suggested a high level of virulence [30,42]. In addition, the antimicrobial activity of B. mucilaginsous159 to other bacterial species, such as E. coli K-12 F + Str. R (KS-507), Salmonella typhimurium LT2, Staphylococcus aureus ATCC 29213, Pseudomonas aeruginosa TO (obtained from the National Bioresource Center All-Russian Collection of Industrial Microorganisms of the Kurchatov Institute (VKPM)), may also be associated with the occurrence of intestinal enteritis in animals [43,44]. Petri dishes with Mueller–Hinton agar medium (BIOLITE SPB, Russia) were pre-seeded with test strains. Then, holes with a diameter of 8 mm were made with sterile metal cylinders. 100 μL of daily culture of strain B. amyloliquefaciens159 at a concentration of 1 × 108 CFU/mL, (grown on nutrient broth of GRM at 37 °C for 24 h) was placed in culture wells. Sterile GRM-bouillon nutrient medium was used as a control. Petri dishes were cultured in an aerostat at 38 °C. The level of antimicrobial activity was assessed after 24 h of growth.
- -
- The bactericidal properties of lauric acid, a component of BFA, were determined. Lauric acid was introduced in concentrations (0.31; 0.16; 0.07 g/L, control without LA) into RCB agar culture medium (MERCK MILLIPORE, USA) to study growth zones of reference C. perfringens strains from ATCC collection (13124, 10543, 12916). Incubated under anaerobic conditions for 48 h.
- -
- The true sorption capacity of diatomite with respect to aflatoxins (sum), ochratoxin A, T-2 toxin, zearalenone, and deoxynivalenol was determined [45]. «True» sorption capacity of this BFA component was determined by the difference between adsorption and desorption of mycotoxins from solutions. «True» sorption capacity of the sorbent was calculated by the following formula:
C = A − D
Adsorption meant the total amount of mycotoxins bound by the sorbent during the time the feed was in an acidic environment (pH = 2.5) simulating the conditions of animal stomach/intestine. To determine mycotoxin adsorption, a standard solution of mycotoxin was prepared with a concentration of 1000 µg/cm3. An exact weigh of 5.0 µg of dry mycotoxin standard (Romer Labs Inc., Getzersdorf, Austria) was dissolved in 5 cm3 of methanol or distilled water (in the case of deoxynivalenol). Diatomite was placed into the solution at a concentration of 0.02 g/mL. The sorption process was carried out for 1 h at 37 °C in the thermostat with constant stirring using a V-1 plus personal vortex (BIOSAN Ltd., Riga, Latvia). The resulting suspension was precipitated by centrifugation for 5 min at 10,000 rpm.
The supernatant and the initial solution were analyzed for mycotoxin content by competitive enzyme immunoassay using Agra Quant test systems (Romer Labs Inc., Austria) according to the manufacturer’s recommendations. Optical density was measured at λ = 450 nm using a Stat Fax 303+ microstrip photometer (Awareness Technology, Inc., Palm City, FL, USA).
Adsorption was calculated using the formula:
where
A = 100 × (Ainitial − Aresidual)/Ainitial
A—adsorption, %;
Ainitial—value of mycotoxin concentration in the initial working solution, μg/cm3;
Aresidual—value of mycotoxin concentration in the working solution after the sorption process, µg/cm3.
To determine desorption, the total amount of mycotoxin removed from the adsorbent surface was measured in an alkaline environment close in pH to the conditions in the ruminant intestine. For this purpose, the obtained suspension containing the adsorbent particles with mycotoxin bound to them was alkalized to pH = 7.0. The suspension was incubated in the thermostat for 1 h at 37 °C with constant stirring using a V-1 plus vortex (Biosan Ltd., Riga, Latvia). The obtained suspension was centrifuged for 5 min at 10,000 rpm.
The supernatant and the initial solution were analyzed for mycotoxin content by ELISA.
2.3. Animals and Housing
The object of the study were Holstein cows (importing country: Hungary). The total number of cattle in Avangard LLC at the time of the study was 1968 milking cows, 274 dry cows and 1467 calves.
For the given experiment, we selected 60 lactating Holstein cows of the second lactation with the average milk yield of 34.16 ± 0.45 kg, days in milking (DIM) = 39.5 ± 1.4 days, fat content = 3.53 ± 0.01% and protein content in milk = 3.05 ± 0.01%. Cows were previously ranked in descending order by DIM, milk yield, fat and protein content in milk, and allocated to control (C, n = 15) and experimental (E48, n = 15; E80, n = 15; E112, n = 15) groups to obtain 48, 80, 112 g/head/day BFA, respectively. This allocation procedure was adopted to ensure that all experimental groups had the same DIM, milk yield and milk parameters at d 0. Feeding of the supplement (specially prepared capsules) was carried out with cows of groups E48–E80–E112 daily in the morning hours after milking with an individual food probe.
Cows were kept in group stalls with unlimited access to water and total mixed ration (TMR; 1.5 m linear cow space per cow) during the whole period of the experiment. Cows were milked twice a day using a carousel system (05-00 and 16-00 h).
2.4. Experimental Diets of Cows
The diet for dairy cows met the energy and nutritional value requirements for high-yielding animals (32–36 kg milk yield) [46,47]. Calculation of feeding rations was carried out by using the software complex KormOptimaExpert (Version 2016, KormoResurs LLC, Voronezh, Russia) (Table 1).
Table 1.
Composition of the diet 1.
The chemical composition of feeds was determined at the Department of Animal Physiology and Biochemistry of the L.K. Ernst Federal Research Center for Animal Husbandry [48]. Feeds were grounded at a Laboratory mill (LMC-1M, NV-Lab, Moscow, Russia) and then analyzed for dry matter (DM) and crude ash (CA) (ISO 6496-83 and ISO 5984, respectively). Initial moisture content was determined by drying the samples at 65 ± 2 °C to constant weight, and drying at 103 ± 2 °C for 3 h to constant sample weight for two successive readings that determined the hygroscopic moisture content of the samples. In dry samples, the raw ash content was determined by burning the sample in a muffle furnace at 550 °C. The nitrogen content was analyzed with ISO 5983-2-2016, from which crude protein (CP) content was calculated with formula (Nitrogen × 6.25), crude fiber with ISO 6865-2015, crude fat ISO 6492:1999, calcium (Ca) ISO 6490-1:1985, phosphorus (P) ISO 6491-2016; ME—calculation method [48,49].
The total duration of the study was 98 days. Cows were fed 48, 80, and 112 g/head/day of BFA during the whole experiment period.
2.5. Milk Performance and Analyses in Milk
Analysis of milk productivity during the experiment and during lactation was conducted according to Dairy Plan C21 (Version 5.285.093). The average daily milk yield was calculated from the results of control milkings before the experiment (d 0), on days 30, 60, 98 within the main period of the experiment (d 30; d 60; d 98). Average daily milk samples on these days were taken from each cow (n = 60) and in them, on an infraspectrometric analyzer (in the Department of Population Genetics and Genetic Bases of Animal Breeding at the L.K. Ernst Federal Research Center for Animal Husbandry) CombiFoss 7 DCC (FOSS, Denmark), fat and protein were determined by standard methods (ISO 9622/IDF 141:2013; AOAC 972. 16). Individual plastic flasks containing bronpol as a preservative were used for milk sampling. Based on the results obtained, the mean values for each indicator were calculated for the animal group before the start of the experiment and at subsequent sampling control points.
2.6. Vaccination and Level of Specific Immunity
All cows were vaccinated with “Coglavax” (vaccine against bovine and sheep clostridial disease, Ceva-Phylaxia VeterinaryBiologicals, Hungary), reinjected two weeks before the experiment. This induces the formation of immune responses in cattle and sheep against alpha, beta, and epsilon anatoxins of C. perfringens types A, B, C, D, and others, from 2–3 weeks after reintroduction, which lasts for 10–12 months. Blood was drawn from animals of the experimental groups at the beginning of the experiment (n = 60, d0) and at the end of the experiment (n = 55, 5 animals dropped out of the experiment, d98). Blood samples from the subcostal vein were collected in vacuum containers (Vacuette, Greiner bioone, Kremsmünster, Austria), with blood clotting activator. Blood samples were stored on ice immediately after extraction and centrifuged 2 h after delivery. All samples were centrifuged at 4 °C at 4500 rpm for 10 min (Tagler centrifuge machine, table model SM-12 with rotor RU-06, NV-LAB, Moscow, Russia). Thereafter, serum samples were stored at −20 °C until analysis. In the Department of Feeding of Farm Animals L.K. Ernst Federal Research Center for Animal Husbandry, the content of antibodies to C. perfringens beta toxin in the blood serum were studied. The studies were performed on an automatic microplate photometer Immunochem-2100 (High Technology Inc, North Attleboro, MA, USA) by solid-phase enzyme immunoassay, using a Monoscreen AbELISA C. perfringens beta toxin reagent kit (BIO K 317/2, Bio-X Diagnostics, Rochefort, Belgique). Blood samples without hemolysis were collected (n = 40 at the beginning of the experiment, n = 50 at the end of the experiment). We also used 2 additional serum samples from animals diagnosed with C. difficile disease as positive controls.
The degree of positivity of each sample was evaluated using a scale (Figure 1).
Figure 1.
Levels for assessing serum sample positivity.
2.7. Molecular Genetic Studies to Detect Some Species of C. perfringens and Their Toxins in the Rumen Contents
Molecular and genetic studies were carried out by the laboratory of Biotroph Ltd. Samples of rumen contents sampled at the end of the experiment (n = 12, 3 animals from each group) and dietary feed (soybean meal, corn grains, DDGS, straw, corn silage; alfalfa haylage) were tested for the presence of toxin genes produced by microorganism C. perfringens: alpha-toxins 1 and 2 (Cpa); beta-toxin (cpb) and epsilon-toxin (ext). The analysis was performed using the PCR method. DNA was isolated using standard methods using the Genomic DNA Purification Kit (Thermo Fisher Scientific, Inc., Waltham, USA) according to the attached instructions. The following specific primers (5′→3′) were chosen for analysis: for the alpha-toxin Cpa gene, F: GCTAATGTTACTGCCGCCGTTGA, R: CCTCTGATACATCGTGTAAGAATC, for the cpb beta-toxin gene—F: GCGAATGCTGAATCATCTA, R: GCAGGAACATTAGTATATCTTC, for the etx epsilon-toxin gene—F: GCGGTGATATCCATCTATTC, R: CCACTTACTTGTCCTACTAAC.
Amplification reactions were performed using a DTLight amplifier (DNA-Technology, Moscow, Russia) and the Tersus Plus PCR kit (Eurogen, Moscow, Russia) according to the manufacturer’s protocol. Mode and conditions of amplification were as follows: 3 min at 94 °C (prewarming); 40 s at 94 °C, 60 s at 55 °C, 90 s at 72 °C (34 cycles).
2.8. Bacterial Strains and Culture Conditions
In the Laboratory of Microbiology of L.K. Ernst Federal Research Center for Animal Husbandry, in selected blood samples, by conventional methods, the indices of nonspecific resistance of experimental animals were determined: bactericidal, lysozyme activity of serum, and phagocytic activity of blood cells.
Strains E. coli ATCC 25922 and M. luteus (lysodeicticus) ATCC 4698 were obtained from Federal Budget Institution of Science «State Research Center for Applied Microbiology & Biotechnology». These bacteria were cultured in Tryptic Soy Agar (TSA) (Merck, Rahway, Germany) at 37 °C for 24 h. The cultures were suspended in phosphate-buffered saline and adjusted by Densi-La-Meret (PLIVA-Lachema Diagnostika, Brno, Czech Republic) for phagocytosis assay to 4.5 McF (E. coli), for bactericidal activity assay to 1.9 McF (E. coli), for lysozyme activity assay to 0.6 McF (M. luteus), and used within 15 min.
2.8.1. Phagocytosis Assay
E. coli culture (0.5 mL) was added to 0.5 mL of blood and incubated on shaker at 37 °C for 30 min. The sediment of mixture was smeared, fixed with 96% methanol, stained with Romanowsky–Giemsa method, and viewed under microscope (90×). E. coli-engulfed neutrophils were counted as positive cells. We analyzed 100 neutrophils per slide. The following parameters were determined:
Phagocytic activity (PA) = (Number of neutrophils involved in phagocytosis/all neutrophils) × 100%;
Phagocytic index (PI) = Number of E. coli cells ingested/100 active neutrophils;
Phagocytic amount (PAM) = Number of phagocytosed bacteria cells/all neutrophils.
2.8.2. Lysozyme Activity Assay
Lysozyme was measured by turbidimetric method in a spectrophotometer USAMultiskan FC (ThermoFisher Scientific Inc., Vantaa, Finland). Tubes of blood serum (0.1 mL) were heated (56 °C) in a water bath for 30 min, then 1.4 mL of standard M. luteus culture was added and incubated at 37 °C for 3 h. The following parameters were determined: lysozyme activity of blood serum (LA), concentration of serum lysozyme (lysozyme, µg/mL), activity unit (AU) per 1 mg protein (AU/TP).
Lysozyme activity (LA) of a blood serum is calculated using the following formula:
%LA = ((ΔDo) × 100/Do1) − ((ΔDk) × 100/Dk1)
- Do is the difference in the optical density of the prototype,
- Dk is the difference in the optical density of the control,
- Do1 is the optical density of the prototype immediately,
- Dk1 is the optical density of the control.
The concentration of lysozyme in serum was calculated based on calibration with dilutions of chicken egg-white lysozyme (L6876, Sigma-Aldrich, St. Louis, MO, USA) ranging from 0.1 to 51.2 µg/mL.
Due to variations in protein content in the blood serum of animals, the level of lysozyme activity was converted and expressed in arbitrary units of activity per 1 mg of protein (activity units per 1 mg of TP or AU/TP).
2.8.3. Bactericidal Activity of Blood Serum
Bactericidal activity (BA) of blood serum was measured by turbidimetric method in a spectrophotometer UNICO-2100 (United products & instruments, Ins., Suite E Dayton, NJ, USA) at OD540. E. coli culture (0.005 mL) was mixed with 4.5 mL of Tryptic Soy Broth (TSB) (Merck, Rahway, Germany) and 0.5 mL of blood serum in sterile tubes. Control was 0.5 mL of physiological saline with phosphate buffer instead of serum. All tubes were cultured at 37 °C for 5 h.
Percentage of BA was calculated from the following formula:
%BA = ((Dk − Do)/Dk)) × 100
- Dk is optical density of control;
- Do is optical density of experimental sample.
2.9. Blood Sampling and Analyses
Blood samples from the jugular vein were collected at the start (d 0) and at the end (d 98) of the main experimental BFA-feeding period at 09-00 h. Blood was collected in vacuum containers (Vacuette, Greiner bio-one, Kremsmünster, Austria), with clotting activator. At the same time, blood was drawn from each cow into vacuum containers (Vacuette, Greiner bio-one, Kremsmünster, Austria) with K3 EDTA. Blood samples were delivered to the Department of Physiology and Biochemistry of Farm Animals of L.K. Ernst Federal Research Center for Animal Husbandry within 2 h. To determine erythrocytes (RDC), leukocytes (WBC), hemoglobin (HGB), and hematocrit (HCT), a hematological analyzer ABC VET analyzer (Horiba ABZ, France) with Uni-Gem reagent kits (ReaMed, Russia) was used. To obtain serum, the samples were centrifuged (3000 rpm) for 20 min, with further storage of the separated serum at −20 °C until analysis. An automatic biochemical analyzer Erba Mannheim automatic XL-640 (Lachema s.r.o., Brno, Czech Republic) was used for analysis with determination of: AST, ALT by UV kinetic method without pyridoxal phosphate, IFCC; ALP—IFCC AM buffer; TP—biuret method; ALB—BKZ method; CREA—Jaffe kinetic method; UREA—Uricase GLDG, kin. method; TBIL—quantification by Walters and Gerarde method; electrolytes: Ca—ARSENAZO III method, P—Ammonium molybdate, Mg—Xylidine blue.
To assess the antioxidant status (AOS), the total amount of water-soluble antioxidants (TAWSA) in blood serum of experimental animals was determined by amperometric method (chromatograph, TsvetYauza 01-AA, SPA Himavtomatika PLC, Moscow, Russia) in samples. The concentrations of TBK-active products were determined using “TBK-Agat” kits (Agat-Med, Russia), and ceruloplasmin (CP) activity was determined using the Revin method. To characterize the prooxidant–antioxidant status of cows, the ratio of TBK-AP to ceruloplasmin (CP) levels was calculated.
2.10. Statistical Analyses
Statistical analyses of the data were performed with STATISTICA software (version 13RU, StatSoft, Inc., 2011; www.statsoft.com (accessed on 27 December 2022)) by using a general linear model. Each group was considered as an experimental unit in measuring milk performance. For analyzing blood characteristic, the experimental units were individual animals. The relationship between the factor and the parameters was revealed using animal sampling, single-factor and two-factor analysis of variance (ANOVA), and Dunnett’s test, with testing of individual measures by Tukey’s multiple comparison method. Statistical differences were considered highly significant at p < 0.01, significant at p < 0.05 and values between p ≥ 0.05 and p ≤ 0.1.
2.11. Ethical Approval
Ethical approval for the study was provided by the bioethical commission of the L.K. Ernst Federal Research Center for Animal Husbandry (protocol #2022-02/1, dated 14 February 2022).
3. Results
3.1. Characteristics and Properties of the Components of the Bioactive Feed Additive (BFA)
The bacterial strain B. amyloliquefaciens159 was found to have pronounced antagonism to toxin-producing strains of C. perfringens. In a study of indicator strains of C. perfringens from the ATCC collection (13124, 10543, 12916), the anti-clostridial activity of strain B. amyloliquefaciens159 varied, with growth retention zones ranging in size from to 14.0 ± 0.95 to 15.0 ± 1.28 mm, at an incubation temperature of 37 °C and exposure for 48 h. These data characterize the strain as a “strain with high antagonistic activity” (Figure 2, Table 2).
Figure 2.
Antagonism of B. amyloliquefaciens159 strain against toxin-producing strains in in vitro experiments (A) C. perfringens 10543, (B) C. perfringens 12916, (C) C. perfringens 13124, 1—growth zone of test microorganism, 2—growth inhibition zone of test microorganism, 3—growth zone of B. amyloliquefaciens159.
Table 2.
Inhibition zones of test cultures influenced by strain B. amyloliquefaciens159 in in vitro experiments.
The sensitivity of the bacterial strains E. coli K-12 F + Str.R (KS-507), Salmonella typhimurium LT2, Staphylococcus aureus ATCC 29213, Pseudomonas aeruginosa TO against B. mucilaginsous 159. The growth inhibition zones of these strains ranged from 8.3 ± 0.61 to 24.1 ± 1.64 mm.
The bactericidal properties of lauric acid in BFA were determined. The addition of lauric acid at concentrations (0.31; 0.16; 0.07 g/L) to RCB media completely suppressed the growth of three C. perfringens reference strains from the ATCC collection (13124, 10543, 12916) (Figure 3, Table 3).
Figure 3.
Bactericidal properties of lauric acid against the toxin-producing strain C. perfringens 13124 in in vitro experiments ((A)—control without LA: 1—sector without test-strain (for control of medium sterility), 2, 3, 4—sectors inoculated with test-strain; (B)—test with addition of LA at 0.16 g/L; (C)—test with addition of LA at 0.07 g/L: 1—sector not seeded with the test strain, 2, 3, 4—sectors seeded with the test strain (no growth of the test strain)).
Table 3.
Growth suppression of C. perfringens strains by lauric acid at different concentrations.
The study of in vitro sorption properties of the studied sorbent—diatomite, as one of the important components of BFA—showed that the true sorption capacity when added to the medium in a concentration of 0.14 g/L was: aflatoxins (sum)—95%, ochratoxin A—30.0%, T-2 toxin—86.3%, zearalenone—36.1%, deoxynivalenol—25.3%.
3.2. Molecular Genetic Studies of Feed and Rumen Contents of Cows
A PCR study detected the presence of the alpha-toxin gene (Cpa) in rumen fluid samples of cows of Group C (No. 1509) and Group E48 (No. 1547; 1118), as well as in feed samples: maize, barley, soya and draff. The presence of the Beta-toxin gene (cpb) was also detected in rumen fluid sample No. 1465 (Group E80) and maize. The epsilon-toxin gene (etx) was also present in the maize sample (Figure 4).
Figure 4.
Agarose gel electrophoresis of alpha, beta and epsilon amplicons of C. perfringens toxin genes detected by polymerase chain reaction in rumen contents and feed ingredients (barley, corn, draff) of lactating cows (Avangard LLC, Russia): C—control group of cows, E48, E80, E112—experimental groups of cows, the symbol “№” and a four-digit number indicates the No.
3.3. Level of Serological Response
The level of serological response increased slightly after three months of experiment in the studied animals as a whole. At the beginning of the experiment, a positive serological response was observed in 42.5% of animals (categories X, XX, XXX, XXXX), at the end of the experiment the level was 48% of the examined samples (Figure 5).
Figure 5.
Level of serological response of animals to C. perfringens β-toxin at the beginning ((A), n = 40) and at the end ((B), n = 50) of the experiment (% inh by C. perfringens β-toxin).
It was noted that, in the animals (2 animals) diagnosed with clostridiosis, an immune response was identified at the level of ˂20 (positivity level “0”).
Analysis of the data by animal group at the beginning of the test showed that the response distribution was almost equal, except for serum samples from Group E112 animals, where the response was the lowest (80% of the samples at the positive “0” level) Figure 6).
Figure 6.
Distribution of samples by response rate and level of occurrence at the beginning of the experiment (n = 10).
At the end of the experiment (3.5 months after vaccination and 3 months after the start of BFA feeding according to the scheme of the experiment), the immune response in the control and Group E48 remained at the same level as at the beginning of the experiment, while the response in Group E80 and E112 was improved by feeding BFA (Figure 7).
Figure 7.
Distribution of levels of positive samples by level of occurrence at the end of the experiment (n = 10–14).
3.4. Level of Non-Specific Resistance
The study of nonspecific resistance of experimental animals in the control and experimental groups at the end of the experiment revealed significant inter-group differences (at the beginning of the experiment, the differences in the studied parameters between the groups were not significant) (Table 4). Feeding on BFA increased the serum lysozyme concentration of experimental cows by 1.01–2.91 mkg/mL compared to the control (p < 0.001).
Table 4.
Indicators of nonspecific resistance of experimental animals 1.
3.5. Blood Parameters of Experimental Animals
At the beginning of the experiment, some blood values were outside the physiologically adequate reference limits (Table 5). Specifically, TP, GLB, AST, and WBC were above the upper limits, while A/G, ALB, Ca/P, and HGB were below the optimum.
Table 5.
Biochemical and morphological parameters of the blood at the start of the experiment (d0) 1.
Blood sampling after 3 months showed that there were some changes under the influence of lactation (Table 6). ALB, AST, Ca/P, and WBC returned to normal, which can be considered positive, but not related to the factor we studied (BFA).
Table 6.
Biochemical and morphological parameters of the blood at the end of the experiment (d98) 1.
Blood parameters such as TP, GLB, ALB/GLB stabilized and normalized in Groups E80 and E112 animals under the influence of BFA feeding vs. Groups C and E48 (p < 0.001). By the end of the experiment, the animals of Groups E80 and E112 had improved nitrogen, fat, and mineral metabolism, as evidenced by the significant increases in ALB (p < 0.05), UREA (p < 0.01), CHOL (p < 0.01), CHL (p < 0.01) vs. Groups C and E48.
Using the amperometric detection method, the serum antioxidant content of the experimental animals was determined at the end of the experiment (Table 7). The lowest value for total water-soluble antioxidants (TAWSA) was found in the serum of control cows, 10.19 mg/g; the highest TAWSA values were in Group E80, 14.45 mg/g (p = 0.002).
Table 7.
Antioxidant blood parameters at the end of the experiment (d98) 1.
The TBA–AP/CP ratio in cow serum was directly related to TBA–AP content (r = 0.87, p < 0.001) and decreased in Group E80 animals.
3.6. Milk Productivity and Milk Content of Dairy Cows
The average daily milk yield of the cows in the experimental groups of cows (d0–d98) was on average 1.24–1.66 kg higher than that of the control. At the same time, Group E112 cows had a significant increase in milk yield (by 5.1%, p = 0.03 vs. Group C) (Figure 8).
Figure 8.
Milk yield of cows (n = 12) of natural fat, kg.
No significant differences in fat and protein content were found in studies of milk composition and quality (Table 8).
Table 8.
Dairy productivity and milk quality parameters during the experiment (average per head).
The effect of BFA feeding was already evident after a 4-week feeding period. Converted to 3.4% fat milk showed a difference in milk yield of 2.8–4.6% (p = 0.02 Group E112 vs. Group C), while fat content in milk of cows from experimental groups was 3.54–3.57 vs. 3.58% (p > 0.05) in control. The slight decrease in milk fat content is explained by the increase in gross milk production.
4. Discussion
In today’s livestock farming conditions, vaccination is a reliable way to control clostridium disease [51]. A vaccine helps the body’s immune system identify and eradicate life-threatening pathogens such as Clostridium. However, due to the widespread distribution of pathogens in the environment, the acute or hyperacute course of the disease, and the severity of tissue damage in the body, treatment of animals is almost 100% ineffective compared to specific prophylaxis [26]. Earlier research [26] had shown that clostridiosis in productive cattle mainly occurs in the form of malignant oedema, with the following prevalence: C. septicum—found in 34.5% of cases, C. perfringens type A—23.25%, C. perfringens type C—14.25%, C. perfringens type D—6.5%, C. oedematiens—2.5%, C. sordellii—6.5%. According to [52] C. perfringens type A (56.66%), type D (26.66%) and type B (16.66%) were, respectively, the most common bacteria in gut samples from 30 cattle and calves with enterotoxemia. On the other hand, there is evidence that dairy cows are not a major source of the potentially pathogenic enterotoxin gene for humans [53]. The type diversity of C. perfringens was low because primarily type A was cultivated. The enterotoxin gene was present in only 0.8% of all isolates. Nevertheless, it poses a serious risk and causes considerable economic damage to the industry [34].
C. perfringens causes several diseases in animals and humans, including histotoxic and intestinal infections. C. perfringens toxins can be divided into major, minor and enterotoxins. Strains of C. perfringens are classified into five toxinotypes (A, B, C, D and E) based on the production of four major toxins. Chromosome-encoded CP toxins type A (CPA) are causative agents of histotoxic infection in humans and animals, and are the leading pathogenetic factors in the development of gas gangrene. The structural genes encoding these toxins, cpa (or plc), are located on the chromosome. CPA activates the extracellular signal-regulated kinase pathway, and thereby induces oxidative stress in the affected cells and the production of interleukin-8 by stimulating the action of kinase and mitogene-activated protein kinase. Beta-toxin SR (CPB), a pore-forming toxin, has a similarity to the amino acid sequence of the pore-forming toxins of Staphylococcus aureus in 20–28% of strains. This toxin is extremely sensitive to trypsin. In vivo, CPB causes necrotizing enteritis in sheep, cattle and horses [28]. Epsilon-toxin CP (ETX) is considered to be the most potent clostridial pore-forming toxin after botulinum and tetanus toxins, and is the cause of necrotizing enteritis and enterotoxemia in sheep, cattle and horses. Thus, the role of each C. perfringens toxin has been established in animal disease, and the mechanism of action of these toxins in vivo has been studied, which makes it possible to develop more effective vaccines against diseases caused by these microorganisms [30].
It is now generally accepted that the unjustified use of antibiotics to prevent and treat infectious diseases causes selection pressure on bacteria, leading to increased antimicrobial resistance and loss of microbial diversity in the environment [54]. Feed additives should be an additional prevention strategy. Therefore, in developing an effective natural feed additive for the prevention of clostridial diseases, we relied on modern approaches to improve the specific and non-specific resistance of livestock. Antimicrobial peptides, immune regulators, probiotics and bacterial toxin binding mannan oligosaccharides [55,56,57] are known to be used as preventive agents. The frequent lack of significant treatment effects, as well as the low reproducibility of the results obtained, leads to the conclusion that, although various feed additives may contribute to the health and immune status of animals, no conclusions can be drawn from these results regarding their effect on the prevention of clostridiosis. According to some researchers [58], high efficacy of treatment and prevention of bovine diseases such as abomasitis, and enteritis caused by C. perfringens, can be achieved by using a comprehensive approach. This should include prevention of C. perfringens proliferation, reduction of exotoxin production, restoration of normal gastrointestinal microflora and gut architecture. The use of probiotic strains selected for the biodegradation of toxic compounds in feed additives is promising [59]. The use of probiotic strains and immunostimulants has great potential as therapy, but requires further development [56,60]. Such bacteria, in addition to their powerful antimicrobial effect, are capable of exerting versatile effects on the host organism. Probiotics, used for prevention or treatment of clostridia, act through multiple possible mechanisms, including the restoration of normobiotic resistance, antagonistic activity, and synthesis of a wide range of metabolites, which have a protective effect on the main targets of Clostridia [61,62,63]. They protect cells from damage and reduce the level of expression (activity) of apoptosis (cell death) and inflammation genes [64,65].
The choice of B. amyloliquefaciens159 as the basis of BFA was based on numerous data [66,67] that suggest that Bacillus bacteria can effectively restore the composition of the host microbiota, increase its resistance to infectious diseases, and contribute to improved animal performance. Currently, various commercial probiotics contain bacilli as active ingredients, due to their ability to colonize the digestive system, their high stability in relation to endosporogenesis, which allows them to survive in stressful situations, such as the aggressive conditions of the internal environment of the body, and their longer shelf life [68]. Representatives of this taxon are known to be capable of synthesis of a wide range of metabolites with antimicrobial properties, including bacteriocins (subtilin, bacillocin 22, sublancin 168 and others) that have an antagonistic effect against a wide range of pathogens [69,70]. In an in vitro experiment, we observed pronounced antimicrobial, particularly anticlostridial, activity of B. amyloliquefaciens159, which was probably due to the diffusion of antimicrobial metabolites into agar. Neutralizing toxins, antioxidants, and increasing the nonspecific resistance of animals can serve as important additions for the complex prophylaxis of clostridiosis. Lauric acid has strong antimicrobial activity due to its function of disordering lipid membranes of microorganisms [66,71]. Pine extract (pycnogenol) has antioxidant activity due to its high content of procyanidides, catechins, polyphenols, as well as antimicrobial and anti-inflammatory properties [72]. We used diatomite as an enterosorbent in BFA. The unique firing technology, at temperatures of 800 °C, significantly increases the specific surface area of the sorbent (up to 40 ha/kg), which makes it the most effective among other sorbents [46,73]. More research is needed to study the use of neutralizers of clostridial toxins, as well as the role of individual substances in the formation of additional animal bioprotection.
In a healthy animal or poultry organism, immunity must perform the task of resisting clostridia. However, antibiotics, often used in the treatment of Clostridia, not only do not increase it, but also reduce it, making the organism more helpless and unable to defend itself [74]. Our study was based on previous findings, that certain strains of the bacteria Bacillus spp. Are biostimulants of non-specific immunity [75]. Some strains are known to reduce the effects of oxidative stress, apoptosis and inflammatory gene expression levels [76]. In addition, pine bark extract, chosen as an ingredient of BFA, is also known for its immunomodulatory properties [77]. The combined action of these components of the feed additive resulted in a significant increase in the level of humoral immunity of cows, which is especially important at the beginning of lactation. The main integral indicators of natural resistance of cattle are the bactericidal (BA) and lysozyme activity (LA) of blood serum. Using the feed additive increased the concentration of lysozyme in the blood serum of cows of group E112 by 3,6 times compared to the control (p < 0.001). BA levels increased by 10.7% (Table 3). It is important to note that vaccines against clostridia are not always effective. In some cases, experts attribute their lack of effectiveness against clostridia to the low level of production in animals of specific antibodies in response to the introduction of the antigen [78]. Prior to the experiment, the animals of the experimental groups were vaccinated with a preparation against bovine clostridiosis. The drug should cause formation of immune response in animals against α-, β- and ε-anatoxins of C. perfringens types A, B, C, D and others, 2–3 weeks after repeated administration, and immunity in this case should be maintained for 10–12 months. The use of BFA in the feeding of dairy cows contributed to a better serological response after immunization with the vaccine and natural contact with C. perfringens. The level of serological response in the control group decreased slightly after three months of experience. At the beginning of the experiment, a positive serological response was observed in 50% of the animals, and at the end of the experiment the serological response rate was 41.6% of the number of animals examined (Figure 5). In contrast, the serological response rate in the experimental groups increased at the end of the experiment. The positive effect of the drug on the effectiveness of vaccination is explained by the fact that the intestinal tract of mammals is the largest immune organ and consists of cells of non-hematopoietic (epithelium, Paneth cells, goblet cells) and hematopoietic (macrophages, dendritic cells, T cells) origin, while simultaneously being a home to symbiotic microbiota, which largely modulate immune cell activity, including through regulation of gene expression [79]. A disturbed microbiome, which is observed in most animals in intensive livestock farming conditions [80], is capable of causing a reduction in vaccination efficacy. Intestinal dysbiosis contributes to systemic inflammation, immunosuppression and a lesser response to vaccines. It has previously been demonstrated in model organisms that dysbiosis reduced specific IgG responses to various vaccines, and the transplantation of fecal commensal microbiota helped to stimulate vaccine responses [81]. Due to the healing of the microbiome and the manifestation of immunomodulatory activity in our experiment, the biopreparation had a positive effect on postvaccination immunity. It is known that the microbiome can influence the efficacy of vaccination through various mechanisms, including direct effects (e.g., through the structural component of the flagellin protein), as well as the synthesis of lipopolysaccharides, volatile fatty acids and other metabolites that can activate Toll-like receptors, and, in turn, stimulate the response of dendritic cells [82]. Thus, Bron et al. [83], after analyzing the available data on the adjuvant activity of three strains of lactobacilli, noted a role in improving vaccination efficacy in compounds such as lipoteichoic acid in Lactiplantibacillus plantarum, the GG (also known as LGG) proteins p40 and p75 secreted by Lacticaseibacillus rhamnosus, and surface layer protein A (SlpA) in L. acidophilus strain NCFM. Earlier results in poultry have also shown that a number of probiotic bacteria increase efficacy against Newcastle disease [84] and avian influenza [85].
Active oxygen species (AOS) are produced during mitochondrial oxidative metabolism as well as in the cellular response to xenobiotics [86] and changes in the rumen microbiome. When AOS suppress the cellular antioxidant defense system, whether by increasing AOS levels or decreasing cellular antioxidant capacity, oxidative stress occurs, affecting the rumen microbiome among others [87]. In turn, it is known that the microbiota of the digestive system can affect the levels of enzymes that metabolize xenobiotics, both in the gut and in the liver [88]. Glutathione (GSH) is present in all mammalian tissues, as the most abundant non-protein thiol that protects the body against oxidative stress [89]. GSH is also a key determinant of redox signaling. Being vital for xenobiotic detoxification, it regulates cell proliferation, apoptosis, immune function and fibrogenesis. GSH biosynthesis occurs in the cytosol in a highly regulated manner. The interrelation of antioxidants and glutathione is caused by their overproduction of indirect biological activity, allowing them to realize their action through signal pathways, mediated by NF-κB and LPS/TLR-4 (proinflammatory cascades), STAT3 and MAR kinases, PI3K/Akt/mTOR (autophagy), and G-protein coupled receptors [90,91,92]. Comparative analysis of the total amount of water-soluble antioxidants is directly related to the induction of ARE-dependent phase II xenobiotic detoxification enzymes and antioxidant enzymes directly involved in the induction of total GST activity in U937 myeloid cells, catalyzing reactions of chemical modification of xenobiotics with GSH participation (conjugation and nucleophilic substitution reactions of xenobiotics and GSH, and reduction of organic peroxides to alcohols with the formation of GSSG). Thus, the accumulation of antioxidants indicates a better level of stress resistance in productive animals, adaptive qualities, and mobility of biochemical pathways in the body under the conditions of intensive milk production. Our data indicate that the feeding of BFA led not only to an increase in TAWSA, but could also improve the antioxidant properties of the milk. The conjugacy of lipid peroxidation and the antioxidant system can be assessed by calculating the correlation between a number of components of these systems and the correlations between them (Table 6). The TBA–AP / CP ratios of blood serum of cows we determined were in direct relation to the TBA–AP content, and decreased in the blood of Group E48 animals (p < 0.01). The highest TBA–AP content was observed in the blood serum of the control group, which probably indicates the activation of free radical processes in cows against the background of high productivity at the beginning of lactation. Thus, the use of BFA significantly improved the antioxidant protection of the body of the experimental animals. We attribute some differences in blood values with physiological norms at the beginning of lactation (Table 4), firstly to the physiological period (cows average 34th day of lactation), secondly to high productivity, and thirdly to feeding. There were intergroup differences (AST, UREA, p < 0.05; WBC, p < 0.01) but they were not systematic. Under the influence of the factor under study, important parameters, such as TP, GLB, A/G, and RDC, stabilized and normalized in the animals of groups E80 and E112, compared to the animals of groups C and E48. Therewith, the following intergroup differences were observed: under the influence of BFA feeding, the TP content in blood serum decreased to normal (p < 0.001), ALB level increased (p < 0.05), and GLB decreased to normal (p < 0.001). This stabilized the A/G-ratio from 0.47–0.49 to 0.64–0.71 (p < 0.001) in the E80 and E112 groups, against the background of urea and ALT increase (p < 0.01). This indicates an optimization of protein metabolism when using BFA, and is also consistent with the higher milk productivity of the experimental groups. Better productivity and milk fat content were connected with the improvement in carbohydrate-lipid metabolism: the blood serum cholesterol concentration in the cows of the experimental groups increased (p < 0.01). GLU in blood of group C animals was below the norm, while in animals of experimental groups its concentration corresponded to the norm (p > 0.05). It is also necessary to note the tendency (p < 0.10) of WBC to decrease in the blood serum of cows in group E112, which reflects the positive effect and characterizes the decrease in inflammatory processes in animals of experimental groups under the influence of BFA. It should be noted that during the three months of the experiment, the cows in the experimental groups maintained their productivity at a high level, unlike the animals in the control group. At the end of the experiment, the average daily milk yield was higher in the experimental groups (Table 7), which indicates not only the ability of the chosen strategy to prevent clostridiosis and improve cattle health and resistance, but also shows the short-term effect expressed in additional milk production.
5. Conclusions
To date, the problem of Clostridial disease remains unresolved. A wide range of clostridial anatoxin, bacteria-anatoxin, or whole culture vaccines are used worldwide to protect animals against the disease [50]. The use of probiotics and holistic supplements for the prevention of clostridiosis is becoming relevant [59,93,94]. The synergy of complementary microorganisms and biologically active substances resulted in the improvement of animal organism resistance, including an increase in organism reactions to the specific β-toxin of C. perfringens. There was a significant improvement of metabolism and increased antioxidant status in cows. When future research in this direction is conducted, it should study the influence of the factor under study on the specific immunity of cows against other kinds of toxins; on rumen metabolism and the microbiological background of the rumen and intestine; on the hormonal background of the animals; and on reproductive ability. This will give an opportunity to assess in a new way the developed method of bovine clostridia prophylaxis. Thus, the use of BFA can serve as a functional technique for the implementation of an animal’s biosecurity strategy against toxins, providing a practically valid technique for future use in farm animal diets. Based on our research, we consider the dosage of 80 g/head/day of BFA to be most appropriate. Studies will continue with this dosage in the future.
Author Contributions
Conceptualization, R.V.N., M.I.L., E.A.Y. and G.Y.L.; methodology, R.V.N., L.A.I., N.V.B., D.A.N. and E.A.Y.; software, R.V.N. and E.S.P.; validation, R.V.N., L.A.I. and K.S.O.; formal analysis, V.A.F., I.G.M., M.G.C., V.C.M., E.P.G. and D.G.T.; investigation, M.I.L. and L.A.I.; resources, R.V.N., M.I.L., L.A.I., N.V.B., D.A.N., E.A.Y. and D.G.T.; data curation, R.V.N., M.I.L., L.A.I., E.A.Y., V.C.M. and E.P.G.; writing—original draft preparation, R.V.N. and E.A.Y.; writing—review and editing, R.V.N., M.I.L., L.A.I., K.S.O. and E.A.Y.; visualization, R.V.N., L.A.I. and E.A.Y.; supervision, R.V.N.; project administration, R.V.N. and G.Y.L.; funding acquisition, R.V.N. and G.Y.L. All authors have read and agreed to the published version of the manuscript.
Funding
This research was financially supported by the Ministry of Science and Higher Education of the Russian Federation (Themes No: 121052600314-1 & 1022041400153-7-2.8.1). The funders had no role in study design, data collection and analysis, decision to publish, or preparation of the manuscript. Therefore, the views expressed herein do not necessarily reflect the official opinion of the donors.
Institutional Review Board Statement
The animal study protocol was approved by the bioethical commission of the L.K. Ernst Federal Research Center for Animal Husbandry (protocol #2022-02/1, dated 14 February 2022). All experiments and conditions (animal care, feeding, biological material sampling, etc.) were fulfilled in accordance with the applicable regulations (internationally recognized guidelines and local acts).
Informed Consent Statement
This study did not involve humans.
Data Availability Statement
Not applicable.
Acknowledgments
The authors gratefully thank the Director and all the staff of Avangard LLC for allowing us access to their farm and animals throughout the experimental period.
Conflicts of Interest
The authors declare no conflict of interest.
References
- Iovdijova, A.; Bencko, V. Potential risk of exposure to selected xenobiotic residues and their fate in the food chain-part I: Classification of xenobiotics. Ann. Agric. Environ. Med. 2010, 17, 183–192. [Google Scholar]
- Acosta de Pérez, O.; Bernacchi, A.S.; Díaz de Toranzo, E.G.; Castro, J.A. Reductive biotransformation of xenobiotics by the sheep ruminal content. Comp. Biochem. Physiol. C 1992, 101, 625–626. [Google Scholar] [CrossRef] [PubMed]
- Walser, V.; Kranzler, M.; Dawid, C.; Ehling-Schulz, M.; Stark, T.D.; Hofmann, T.F. Distribution of the Emetic Toxin Cereulide in Cow Milk. Toxins 2021, 13, 528. [Google Scholar] [CrossRef] [PubMed]
- Panter, K.E.; Stegelmeier, B.L. Effects of xenobiotics and phytotoxins on reproduction in food animals. Vet. Clin. North Am. Food Anim. Pract. 2011, 27, 429–446. [Google Scholar] [CrossRef] [PubMed]
- Nag, S.K.; Raikwar, M.K. Persistent organochlorine pesticide residues in animal feed. Environ. Monit. Assess. 2011, 174, 327–335. [Google Scholar] [CrossRef] [PubMed]
- Marin, D.E.; Pistol, G.C.; Procudin, C.V.; Taranu, I. Co-Contamination of Food and Feed with Mycotoxin and Bacteria and Possible Implications for Health. Agriculture 2022, 12, 1970. [Google Scholar] [CrossRef]
- Zhang, F.; Li, Y.; Yang, M.; Li, W. Content of heavy metals in animal feeds and manures from farms of different scales in northeast. China Int. J. Environ. Res. Public Health 2012, 9, 2658–2668. [Google Scholar] [CrossRef]
- Curpan, A.; Impellitteri, F.; Plavan, G.; Ciobica, A.; Faggio, C. Mytilus galloprovincialis: An essential, low-cost model organism for the impact of xenobiotics on oxidative stress and public health. Comp. Biochem. Physiol. C Toxicol. Pharmacol. 2022, 256, 109302. [Google Scholar] [CrossRef]
- El-Demerdash, F.; Tousson, E.; Kurzepa, J.; Habib, S. Xenobiotics, Oxidative Stress, and Antioxidants. Oxid. Med. Cell Longev. 2018, 2018, 9758951. [Google Scholar] [CrossRef]
- Surai, P.F.; Kochish, I.I.; Fisinin, V.I.; Juniper, D.T. Revisiting Oxidative Stress and the Use of Organic Selenium in Dairy Cow Nutrition. Animals 2019, 9, 462. [Google Scholar] [CrossRef]
- Rodrigues, I. A review on the effects of mycotoxins in dairy ruminants. Anim. Prod. Sci. 2014, 54, 1155–1165. [Google Scholar] [CrossRef]
- Hu, H.; Mu, T.; Ma, Y.; Wang, X.; Ma, Y. Analysis of Longevity Traits in Holstein Cattle: A Review. Front. Genet. 2021, 12, 695543. [Google Scholar] [CrossRef] [PubMed]
- Hadley, G.L.; Awolf, C.; Harsh, S.B. Dairy cattle culling patterns, explanations, and implications. J. Dairy Sci. 2006, 89, 2286–2296. [Google Scholar] [CrossRef] [PubMed]
- Gallo, A.; Giuberti, G.; Frisvad, J.C.; Bertuzzi, T.; Nielsen, K.F. Review on Mycotoxin Issues in Ruminants: Occurrence in Forages, Effects of Mycotoxin Ingestion on Health Status and Animal Performance and Practical Strategies to Counteract Their Negative Effects. Toxins 2015, 7, 3057–3111. [Google Scholar] [CrossRef] [PubMed]
- Pavelić, S.K.; Medica, J.S.; Gumbarević, D.; Filošević, A.; Pržulj, N.; Pavelić, K. Critical review on zeolite clinoptilolite safety and medical applications in vivo. Front. Pharmacol. 2018, 9, 1350. [Google Scholar] [CrossRef] [PubMed]
- Hegazy, A.; Khalifa, M.; Nasr, S. Monitoring of Carcinogenic Environmental Pollutants in raw Cows’ Milk. Biomed. Pharmacol. J. 2019, 11, 435–442. [Google Scholar] [CrossRef]
- Liew, W.P.; Mohd-Redzwan, S. Mycotoxin: Its Impact on Gut Health and Microbiota. Front Cell Infect. Microbiol. 2018, 26, 60. [Google Scholar] [CrossRef]
- Sotnichenko, A.; Tsis, E.; Chabaev, M.; Duborezov, V.; Kochetkov, A.; Nekrasov, R.; Okhanov, V. Protection and Active Decontamination of Dairy Cattle Heifers against Lipophilic Toxins (PCBs) from Diet. Toxics 2021, 9, 80. [Google Scholar] [CrossRef]
- Ogunade, I.M.; Martinez-Tuppia, C.; Queiroz, O.C.M.; Jiang, Y.; Drouin, P.; Wu, F.; Vyas, D.; Adesogan, A.T. Silage review: Mycotoxins in silage: Occurrence, effects, prevention, and mitigation. J. Dairy Sci. 2018, 101, 4034–4059. [Google Scholar] [CrossRef]
- Gallo, A.; Minuti, A.; Bani, P.; Bertuzzi, T.; Piccioli Cappelli, F.; Doupovec, B.; Faas, J.; Schatzmayr, D.; Trevisi, E. A mycotoxin-deactivating feed additive counteracts the adverse effects of regular levels of Fusarium mycotoxins in dairy cows. J. Dairy Sci. 2020, 103, 11314–11331. [Google Scholar] [CrossRef]
- Kırkan, Ş.; Parın, U.; Dönmez, E.; Dolgun, H. Bacterial Toxins. Anim. Health Prod. Hyg. 2020, 9, 727–733. [Google Scholar]
- Field, M. Cholera Toxin, Adenylate Cyclase, and the Process of Active Secretion in the Small Intestine: The Pathogenesis of Diarrhea in Cholera. In Physiology of Membrane Disorders; Andreoli, T.E., Ed.; Plenum Publishing Corporation: New York, NY, USA, 1978; pp. 877–889. [Google Scholar] [CrossRef]
- Fowler, C.C.; Chang, S.J.; Gao, X.; Geiger, T.; Stack, G.; Galán, J.E. Emerging insights into the biology of typhoid toxin. Curr. Opin. Microbiol. 2017, 14, 70–77. [Google Scholar] [CrossRef] [PubMed]
- Freedman, J.C.; Shrestha, A.; McClane, B.A. Clostridium perfringens Enterotoxin: Action, Genetics, and Translational Applications. Toxins 2016, 8, 73. [Google Scholar] [CrossRef] [PubMed]
- Lebrun, M.; Mainil, J.; Linden, A. Cattle enterotoxaemia and Clostridium perfringens: Description, diagnosis and prophylaxis. Vet. Rec. 2010, 167, 13–22. [Google Scholar] [CrossRef]
- Kapustin, A.V.; Laishevtcev, A.I.; Ivanov, E.V.; Danilyuk, A. Species diversity of Clostridia causing malignant edema in cattle. IOP Conf. Ser. Earth Environ. Sci. 2020, 548, 72041. [Google Scholar] [CrossRef]
- Songer, J.G. Clostridial enteric diseases of domestic animals. Clin. Microbiol. Rev. 1996, 9, 216–234. [Google Scholar] [CrossRef]
- Tsiouris, V.S.; Georgopoulou, I.; Petridou, E. Update on the toxins of Clostridium perfringens and their actions. J. Hell. Vet. Med. Soc. 2017, 61, 241–252. [Google Scholar] [CrossRef]
- Shrestha, A.; Uzal, F.A.; McClane, B.A. Enterotoxic Clostridia: Clostridium perfringens Enteric Disease. Microbiol. Spectr. 2018, 6, 6.5.07. [Google Scholar] [CrossRef]
- Uzal, F.A.; Vidal, J.E.; McClane, B.A.; Gurjar, A.A. Clostridium Perfringens Toxins Involved in Mammalian Veterinary Diseases. Open Toxinol. J. 2010, 2, 24–42. [Google Scholar] [CrossRef]
- Jerram, L. Clostridial disease in cattle. Livestock 2019, 24, 274–279. [Google Scholar] [CrossRef]
- König, W. Effects of Ensilability Traits of Forage Legumes and Additives on Silage Quality Assessed by Fermentation Pattern and qPCR Quantification of Clostridia; Helsingin Yliopisto: Helsinki, Finland, 2020. [Google Scholar]
- Debevere, S.; Schatzmayr, D.; Reisinger, N.; Aleschko, M.; Haesaert, G.; Rychlik, M.; Croubels, S.; Fievez, V. Evaluation of the Efficacy of Mycotoxin Modifiers and Mycotoxin Binders by Using an In Vitro Rumen Model as a First Screening Tool. Toxins 2020, 12, 405. [Google Scholar] [CrossRef] [PubMed]
- Compiani, R.; Grossi, S.; Lucini, L.; Sgoifo Rossi, C.A. Prevention of the main Clostridial diseases in cattle. LAR 2021, 27, 51–56. [Google Scholar]
- Ministry of Health. Guidelines of the Ministry of Health of the USSR MU 2620-82, Guidelines for Hygienic Evaluation of Microbial Plant Protection Agents against Insects and Diseases Based on Non-Associated Microorganisms; Ministry of Health: Kiev, Ukraine, 1982. [Google Scholar]
- RGMU. Methodical Recommendations of RGMU; Criteria for Evaluation of Pathogenic Properties of Strain Producers Proposed for Use in Biological Synthesis Industry; RGMU: Ryazan, Russia, 1992. [Google Scholar]
- WHO. WHO Recommendations. Bull. WHO 1982, 6, 20–27. [Google Scholar]
- Institute of Medicine (US) Committee on Resource Sharing in Biomedical Research. Resource Sharing in Biomedical Research; Berns, K.I., Bond, E.C., Manning, F.J., Eds.; National Academies Press (US): Washington, DC, USA, 1996. [Google Scholar]
- The American Type Culture Collection. Available online: https://www.ncbi.nlm.nih.gov/books/NBK209072/ (accessed on 20 February 2023).
- Ministry of Health of the Russian Federation. GPhM. 1.7.2.0009.15. Determination of the Specific Activity of Probiotics; Ministry of Health of the Russian Federation Publ.: Moscow, Russia, 2015; 24p. [Google Scholar]
- Lobzin, Y.V.; Kvetnaya, A.S.; Skripchenko, N.V.; Zhelezova, L.I. Current notions about etiopathogenic and genetics specific features of Clostridium perfringens toxins. J. Microbiol. Epidemiol. Immunobiol. 2021, 98, 91–103. [Google Scholar] [CrossRef]
- Cheung, J.K.; Dupuy, B.; Deveson, D.S.; Rood, J.I. The spatial organization of the VirR boxes is critical for VirR-mediated expression of the perfringolysin O gene, pfoA, from Clostridium perfringens. J. Bacteriol. 2004, 186, 3321–3330. [Google Scholar] [CrossRef]
- Kylla, H.; Dutta, T.K.; Roychoudhury, P.; Subudhi, P.K. Coinfection of diarrheagenic bacterial and viral pathogens in piglets of Northeast region of India. Vet. World 2019, 12, 224–230. [Google Scholar] [CrossRef]
- 8 EFSA Panel on Animal Health and Welfare (AHAW); Nielsen, S.S.; Bicout, D.J.; Calistri, P.; Canali, E.; Drewe, J.A.; Garin-Bastuji, B.; Gonzales Rojas, J.L.; Gortazar Schmidt, C.; Herskin, M.; et al. Assessment of animal diseases caused by bacteria resistant to antimicrobials: Dogs and cats. EFSA J. 2021, 19, e06680. [Google Scholar] [CrossRef]
- Yıldırım, E.A. Theoretical and Experimental Bases of Microbiological Safety of Preserved Feeds for Ruminant Farm Animals. Ph.D. Thesis, L.K. Ernst Federal Research Center for Animal Husbandry, Podolsk, Russia, 2019. [Google Scholar]
- National Academies Press. Nutrient Requirements of Dairy Cattle, 7th ed.; National Academies Press: Washington, DC, USA, 2001. [Google Scholar]
- Nekrasov, R.V.; Golovin, A.V.; Makhaev, E.A. Nutrient Requirements of Dairy Cattle and Pigs; L.K. Ernst Federal Research Center for Animal Husbandry: Moscow, Russia, 2018. [Google Scholar]
- AOAC. Official Methods of Analysis of the Association of Analytical Chemists; AOAC: Arlington, VA, USA, 1995. [Google Scholar]
- Kirilov, M.P.; Mahaev, E.A.; Pervov, N.G.; Puzanova, V.V.; Anikin, A.S. The Method of Calculating the Metabolic Energy in Feed Based on the Content of Raw Nutrients; L.K. Ernst Federal Research Center for Animal Husbandry: Dubrovitsy, Russia, 2008. [Google Scholar]
- Gusev, I.V.; Bogolyubova, N.V.; Rykov, R.A.; Levina, G.N. Control of the Biochemical Status of Pigs and Cows: A Guide; L.K. Ernst Federal Research Center for Animal Husbandry: Dubrovitsy, Russia, 2019. [Google Scholar]
- Khiav, L.; Zahmatkesh, A. Vaccination against pathogenic clostridia in animals: A review. Trop. Anim. Health Prod. 2021, 53, 284. [Google Scholar] [CrossRef]
- Sasani, F.; Marzban, H.; Javanbakht, J.; Moosakhani, F.; Imanparast, M. The Relationship between Microscopic Lesions and Different Types of Clostridium perfringens and their Related Toxins by Sandwich ELISA in Cattle. J. Microb. Biochem. Technol. 2013, 5, 34–38. [Google Scholar] [CrossRef]
- Fohler, S.; Klein, G.; Hoedemaker, M.; Scheu, T.; Seyboldt, C.; Campe, A.; Jensen, K.C.; Abdulmawjood, A. Diversity of Clostridium perfringens toxin-genotypes from dairy farms. BMC Microbiol. 2016, 16, 199. [Google Scholar] [CrossRef]
- Checcucci, A.; Trevisi, P.; Luise, D.; Modesto, M.; Blasioli, S.; Braschi, I.; Mattarelli, P. Exploring the animal waste resistome: The spread of antimicrobial resistance genes through the use of livestock manure. Front. Microbiol. 2020, 11, 1416. [Google Scholar] [CrossRef] [PubMed]
- Brady, J.; Hernandez-Doria, J.D.; Bennett, C.; Guenter, W.; House, J.D.; Rodríguez-Lecompte, J.C. Toxinotyping of necrotic enteritis-producing and commensal isolates of Clostridium perfringens from chickens fed organic diets. Avian Pathol. 2010, 39, 475–481. [Google Scholar] [CrossRef] [PubMed]
- MBFArland, L.V. Emerging therapies for Clostridium difficile infections. Expert Opin. Emerg. Drugs 2011, 16, 425–439. [Google Scholar] [CrossRef] [PubMed]
- Lucey, P.M.; Lean, I.J.; Aly, S.S.; Golder, H.M.; Block, E.; Thompson, J.S.; Rossow, H.A. Effects of mannan-oligosaccharide and Bacillus subtilis supplementation to preweaning Holstein dairy heifers on body weight gain, diarrhea, and shedding of fecal pathogens. J. Dairy Sci. 2021, 104, 4290–4302. [Google Scholar] [CrossRef]
- Simpson, K.M.; Callan, R.J.; Van Metre, D.C. Clostridial Abomasitis and Enteritis in Ruminants. Vet. Clin. North. Am. Food Anim. Pract. 2018, 34, 155–184. [Google Scholar] [CrossRef]
- Cull, C.; Singu, V.K.; Cull, B.J.; Lechtenberg, K.F.; Amachawadi, R.G.; Schutz, J.S.; Bryan, K.A. Efficacy of Two Probiotic Products Fed Daily to Reduce Clostridium perfringens-Based Adverse Health and Performance Effects in Dairy Calves. Antibiotics 2022, 11, 1513. [Google Scholar] [CrossRef]
- Goldenberg, J.Z.; Ma, S.S.; Saxton, J.D.; Martzen, M.R.; Vandvik, P.O.; Thorlund, K.; Guyatt, G.H.; Johnston, B.C. Probiotics for the prevention of Clostridium difficile-associated diarrhea in adults and children. Cochrane Database Syst. Rev. 2013, 31, CD006095. [Google Scholar] [CrossRef]
- Theriot, C.M.; Young, V.B. Interactions Between the Gastrointestinal Microbiome and Clostridium difficile. Annu. Rev. Microbiol. 2015, 69, 445–446. [Google Scholar] [CrossRef]
- Hudson, L.E.; Anderson, S.E.; Corbett, A.H.; Lamb, T.J. Gleaning Insights from Fecal Microbiota Transplantation and Probiotic Studies for the Rational Design of Combination Microbial Therapies. Clin. Microbiol. Rev. 2017, 30, 191–231. [Google Scholar] [CrossRef]
- Mills, J.P.; Rao, K.; Young, V.B. Probiotics for prevention of Clostridium difficile infection. Curr. Opin. Gastroenterol. 2018, 34, 3–10. [Google Scholar] [CrossRef]
- Patra, S.; Sahu, N.; Saxena, S.; Pradhan, B.; Nayak, S.K.; Roychowdhury, A. Effects of Probiotics at the Interface of Metabolism and Immunity to Prevent Colorectal Cancer-Associated Gut Inflammation: A Systematic Network and Meta-Analysis with Molecular Docking Studies. Front. Microbiol. 2022, 27, 878297. [Google Scholar] [CrossRef] [PubMed]
- Caly, D.L.; D’Inca, R.; Auclair, E.; Drider, D. Alternatives to Antibiotics to Prevent Necrotic Enteritis in Broiler Chickens: A Microbiologist’s Perspective. Front. Microbiol. 2015, 6, 1336. [Google Scholar] [CrossRef] [PubMed]
- Tran, C.; Cock, I.E.; Chen, X.; Feng, Y. Antimicrobial Bacillus: Metabolites and Their Mode of Action. Antibiotics 2022, 11, 88. [Google Scholar] [CrossRef] [PubMed]
- Ding, H.; Zhao, X.; Ma, C.; Gao, Q.; Yin, Y.; Kong, X.; He, J. Dietary supplementation with Bacillus subtilis DSM 32315 alters the intestinal microbiota and metabolites in weaned piglets. J. Appl. Microbiol. 2021, 130, 217–232. [Google Scholar] [CrossRef] [PubMed]
- Luise, D.; Bosi, P.; Raff, L.; Amatucci, L.; Virdis, S.; Trevisi, P. Bacillus spp. Probiotic Strains as a Potential Tool for Limiting the Use of Antibiotics, and Improving the Growth and Health of Pigs and Chickens. Front. Microbiol. 2022, 13, 801827. [Google Scholar] [CrossRef]
- Luo, X.Z.; Shi, B.H.; Zheng, H.; Wei-Bin, W.U.; Shi, Q.Q. Physical and chemical properties and antimicrobial spectrum of subtilin from Bacillus subtilis FB123. J. Microbiol. 2008, 28, 64–67. [Google Scholar]
- Hristov, A.N.; Vander Pol, M.; Agle, M.; Zaman, S.; Schneider, C.; Ndegwa, P.; Vaddella, V.K.; Johnson, K.; Shingfield, K.J.; Karnati, S.K.R. Effect of lauric acid and coconut oil on ruminal fermentation, digestion, ammonia losses from manure, and milk fatty acid composition in lactating cows. J. Dairy Sci. 2009, 92, 5561–5582. [Google Scholar] [CrossRef]
- Rebucci, R.; Comi, M.; Ghiringhelli, M.; Giorgi, S.; Cheli, F.; Bontempo, V. Lauric acid saponified with calcium ameliorates indices of intestinal function and gut health in weaned piglets. Ital. J. Anim. Sci. 2021, 20, 1479–1490. [Google Scholar] [CrossRef]
- Simpson, T.; Kure, C.; Stough, C. Assessing the Efficacy and Mechanisms of Pycnogenol® on Cognitive Aging From In Vitro Animal and Human Studies. Front. Pharmacol. 2019, 10, 694. [Google Scholar] [CrossRef]
- Popovich, J.; Chen, S.; Iannuzo, N.; Ganser, C.; Seo, D.K.; Haydel, S.E. Synthesized Geopolymers Adsorb Bacterial Proteins, Toxins, and Cells. Front. Bioeng. Biotechnol. 2020, 8, 527. [Google Scholar] [CrossRef]
- Benou, J.M.; Labuda, J.C.; McSorley, S.J. Collateral Damage: Detrimental Effect of Antibiotics on the Development of Protective Immune Memory. mBio 2016, 7, e01520-16. [Google Scholar] [CrossRef]
- Lefevre, M.; Racedo, S.M.; Ripert, G.; Housez, B.; Cazaubiel, M.; Maudet, C.; Jüsten, P.; Marteau, P.; Urdaci, M.C. Probiotic strain Bacillus subtilis CU1 stimulates immune system of elderly during common infectious disease period: A randomized, double-blind placebo-controlled study. Immun. Ageing 2015, 12, 24. [Google Scholar] [CrossRef] [PubMed]
- Tang, L.; Zeng, Z.; Zhou, Y.; Wang, B.; Zou, P.; Wang, Q.; Ying, J.; Wang, F.; Li, X.; Xu, S.; et al. Bacillus amyloliquefaciens SC06 Induced AKT-FOXO Signaling Pathway-Mediated Autophagy to Alleviate Oxidative Stress in IPEC-J2 Cells. Antioxidants 2021, 10, 1545. [Google Scholar] [CrossRef] [PubMed]
- Verlaet, A.; van der Bolt, N.; Meijer, B.; Breynaert, A.; Naessens, T.; Konstanti, P.; Smidt, H.; Hermans, N.; Savelkoul, H.F.J.; Teodorowicz, M. Toll-Like Receptor-Dependent Immunomodulatory Activity of Pycnogenol®. Nutrients 2019, 11, 214. [Google Scholar] [CrossRef]
- Tishchenko, A.S.S.; Terekhov, V.I. Infectious Diseases of Animals: Clostridial Disease and Other Anaerobic Infections; Lan’: St. Petersburg, Russia, 2021. [Google Scholar]
- Chassaing, B.; Kumar, M.; Baker, M.T.; Singh, V.; Vijay-Kumar, M. Mammalian gut immunity. Biomed J. 2014, 37, 246–258. [Google Scholar] [CrossRef]
- Laptev, G.Y.; Yildirim, E.A.; Dunyashev, T.P.; Ilyina, L.A.; Tyurina, D.G.; Filippova, V.A.; Brazhnik, E.A.; Tarlavin, N.V.; Dubrovin, A.V.; Novikova, N.I.; et al. Biodiversity and predicted metabolic functions of the rumen microbiota depending on feeding habits at different stages of the physiological cycle of dairy cows. Sel’skokhozyaistvennaya Biol. Agric. Biol. 2021, 56, 619–640. [Google Scholar] [CrossRef]
- Lynn, M.A.; Tumes, D.J.; Choo, J.M.; Sribnaia, A.; Blake, S.J.; Leong, L.E.X.; Young, G.P.; Marshall, H.S.; Wesselingh, S.L.; Rogers, G.B. Early-life antibiotic driven dysbiosis leads to dysregulate vaccine immune responses in mice. Cell Host Microbe 2018, 23, 653–660. [Google Scholar] [CrossRef]
- Peroni, D.G.; Morelli, L. Probiotics as Adjuvants in Vaccine Strategy: Is There More Room for Improvement? Vaccines 2021, 9, 811. [Google Scholar] [CrossRef]
- Bron, P.A.; van Baarlen, P.; Kleerebezem, M. Emerging molecular insights into the interaction between probiotics and the host intestinal mucosa. Nat. Rev. Microbiol. 2011, 10, 66–78. [Google Scholar] [CrossRef]
- Nouri Gharajalar, S.; Mirzai, P.; Nofouzi, K.; Madadi, M.S. Immune enhancing effects of Lactobacillus acidophilus on Newcastle disease vaccination in chickens. Comp. Immunol. Microbiol. Infect. Dis. 2020, 72, 101520. [Google Scholar] [CrossRef]
- Alqazlan, N.; Astill, J.; Taha-Abdelaziz, K.; Nagy, É.; Bridle, B.; Sharif, S. Probiotic Lactobacilli Enhance Immunogenicity of an Inactivated H9N2 Influenza Virus Vaccine in Chickens. Viral Immunol. 2021, 34, 86–95. [Google Scholar] [CrossRef] [PubMed]
- Klotz, L.O.; Steinbrenner, H. Cellular adaptation to xenobiotics: Interplay between xenosensors, reactive oxygen species and FOXO transcription factors. Redox Biol. 2017, 13, 646–654. [Google Scholar] [CrossRef] [PubMed]
- Kim, S.H.; Ramos, S.C.; Valencia, R.A.; Cho, Y.I.; Lee, S.S. Heat Stress: Effects on Rumen Microbes and Host Physiology, and Strategies to Alleviate the Negative Impacts on Lactating Dairy Cows. Front. Microbiol. 2022, 13, 804562. [Google Scholar] [CrossRef] [PubMed]
- Meinl, W.; Sczesny, S.; Brigelius-Flohé, R.; Blaut, M.; Glatt, H. Impact of gut microbiota on intestinal and hepatic levels of phase 2 xenobiotic-metabolizing enzymes in the rat. Drug Metab. Dispos. 2009, 37, 1179–1186. [Google Scholar] [CrossRef] [PubMed]
- Lu, S.C. Glutathione synthesis. Biochim. Biophys. Acta 2013, 1830, 3143–3153. [Google Scholar] [CrossRef] [PubMed]
- Zhou, Y.; Gong, X.; Zhang, H.; Peng, C. Review on the pharmacokinetics of paeoniflorin and its anti-inflammatory and immunomodulatory effects. Biomed. Pharmacother. 2020, 30, 110505. [Google Scholar] [CrossRef]
- Zenkov, N.; Kozhin, P.; Chechushkov, A.; Martinovich, G.; Kandalintseva, N.; Menshchikova, E. Mazes of Nrf2 regulation. Biochemistry 2017, 82, 556–564. [Google Scholar] [CrossRef]
- Rolt, A.; Cox, L. Structural basis of the antiageing effects of polyphenolics: Mitigation of oxidtive stress. BMC Chem. 2020, 14, 50. [Google Scholar] [CrossRef]
- Merati, R.; Mohamed, A.A.A.-F.; Berrama, Z.; Aggad, H.; Hammoudi, A.; Temim, S. The effects of Pediococcus acidilactici and Saccharomyces cerevisiae on broiler chickens challenged with Clostridium perfringens induced subclinical necrotic enteritis. Vet. Arhiv. 2021, 91, 389–397. [Google Scholar] [CrossRef]
- La Ragione, R.M.; Casula, G.; Cutting, S.M.; Woodward, M.J. Bacillus subtilis spores competitively exclude Escherichia coli O87, K80 in poultry. Vet. Microbiol. 2001, 79, 133–142. [Google Scholar] [CrossRef]
Disclaimer/Publisher’s Note: The statements, opinions and data contained in all publications are solely those of the individual author(s) and contributor(s) and not of MDPI and/or the editor(s). MDPI and/or the editor(s) disclaim responsibility for any injury to people or property resulting from any ideas, methods, instructions or products referred to in the content. |
© 2023 by the authors. Licensee MDPI, Basel, Switzerland. This article is an open access article distributed under the terms and conditions of the Creative Commons Attribution (CC BY) license (https://creativecommons.org/licenses/by/4.0/).